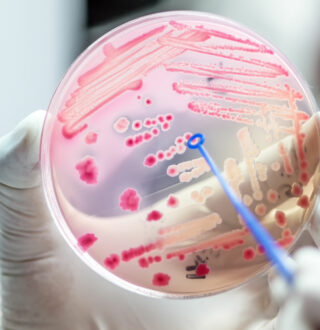
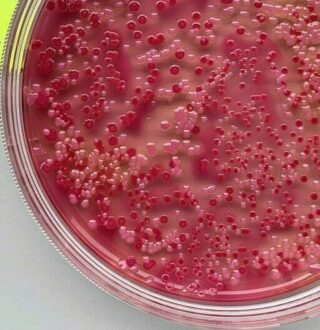

Antimicrobial Resistance (AMR)
After a chat about antimicrobial resistance (AMR) between Prof. Markus Seeger at the University of Zurich and Swissnex in India’s Dr. Lena Robra, Markus suggested that a good way to build more knowledge on AMR would be for Swiss researchers to interact with Indian researchers working on AMR. The University of Geneva also expressed interest in the topic. Following these conversations, we organised the Indo-Swiss AMR Innovation Dialogue, where 50 Swiss and Indian experts gathered in Bengaluru to discuss roadblocks in AMR innovation, progress on research, the gaps that need to be filled, the skills needed to fill these gaps, innovative approaches that could be used to confront the AMR crisis and collaborations that could facilitate the process. We invited participants from various fields in the health sector, including clinicians, doctors, pharma companies, startups and investors, so that all the required skills could be found in one room. As a result of the AMR Dialogue, today there are at least five new partnerships. Indian students are spending time in Swiss research labs, an Indian researcher is testing a molecule for a Swiss company that he met at the AMR Dialogue, and a future dialogue in Switzerland is in the works. Our aim is to not just connect people but to facilitate meaningful and lasting partnerships and relationships of trust that lead to innovative solutions.
Planetary Health
Another significant outcome of the AMR Dialogue is our participation in the Trialogue Days, a three-day gathering hosting participants from India, Switzerland and Uganda at the Indian Institute of Science (IISc) in Bengaluru on planetary health. Trialogue Days is an extension of Dialogue Days, a 10-year partnership on infectious diseases and One Health between Makerere University and the University of Zurich. At the AMR Dialogue, Prof. Jan Fehr at the University of Zurich and Prof. Utpal Tatu at IISc—who had collaborated and decided to host the Trialogue Days at the IISc—took note of how we had selected and connected different stakeholders and Jan invited us to be part of it. Fifty experts from the three countries will come together in December of 2024 to talk about the impacts of heat, air quality, water and flooding; the risks attached to zoonotic diseases (diseases spread between humans and animals), AMR, global mobility and migration; and the opportunities offered through resilient health systems, mitigation and adaptation, better education and new technologies. The theme of the Trialogue Days is ‘Planetary Health from Different Perspectives – Mind the Gap’, and the idea is to highlight the need to increase transdisciplinary knowledge and exchange experiences to be able to counter the pressing challenges of planetary health.
Collaborative Online International Learning (COIL)
During the COVID-19 pandemic, we partnered with Movetia, Switzerland’s national agency responsible for promoting exchange and mobility within the Swiss education system, where we identified gaps and roadblocks in digital skills in higher education in Switzerland and wrote a report delving into the issues. Building on this partnership with Movetia and involving other international facilitators, we co-developed an online course that would enhance teaching through global collaboration and intercultural learning—Collaborative Online International Learning (COIL). The intent was two-fold: first to enhance digital teaching skills and second to increase access to internationalisation at home. We actively support COILs and help co-develop them for organisations and institutions.
Knowledge2Action
We help in bridging the gap between Switzerland and India’s innovation, education and research collaborations. One of the programmes offered by the Clusters of Cooperation in the Global South (CLOC) and sponsored by swissuniversities Development and Cooperation Network (SUDAC) is the Knowledge2Action programme, which promotes the real-world application of research findings in South Asia and Switzerland and focuses on environmental sustainability and social well-being goals. We oversee the implementation of the K2A projects, facilitate sharing of research findings and knowledge exchange via workshops and conferences. Under the K2A, there are several funding instruments available including the K2A Small Grants, K2A Mobility Subsidies and the K2A Online Academy. The idea is to make knowledge and research from Swiss and South Asian institutions accessible to a wide variety of stakeholders that promote the United Nations’ Sustainable Development Goals. These actors include but are not limited to policymakers, educators, activists and others who can put knowledge to action.
Building Student Experience
We also organise study tours in India for Swiss students to provide them with a global experience so that they learn to look at things from a different perspective in a different country. An example of how we carried this out began in 2022, when selected students who had submitted their projects and ideas as part of the University of Lausanne’s course on social development and the environment, were given the opportunity to visit India. We developed a programme for them—that included site visits and stakeholder engagements in the water sector—that made a lasting impression on them and offered them the impetus to do something impactful.